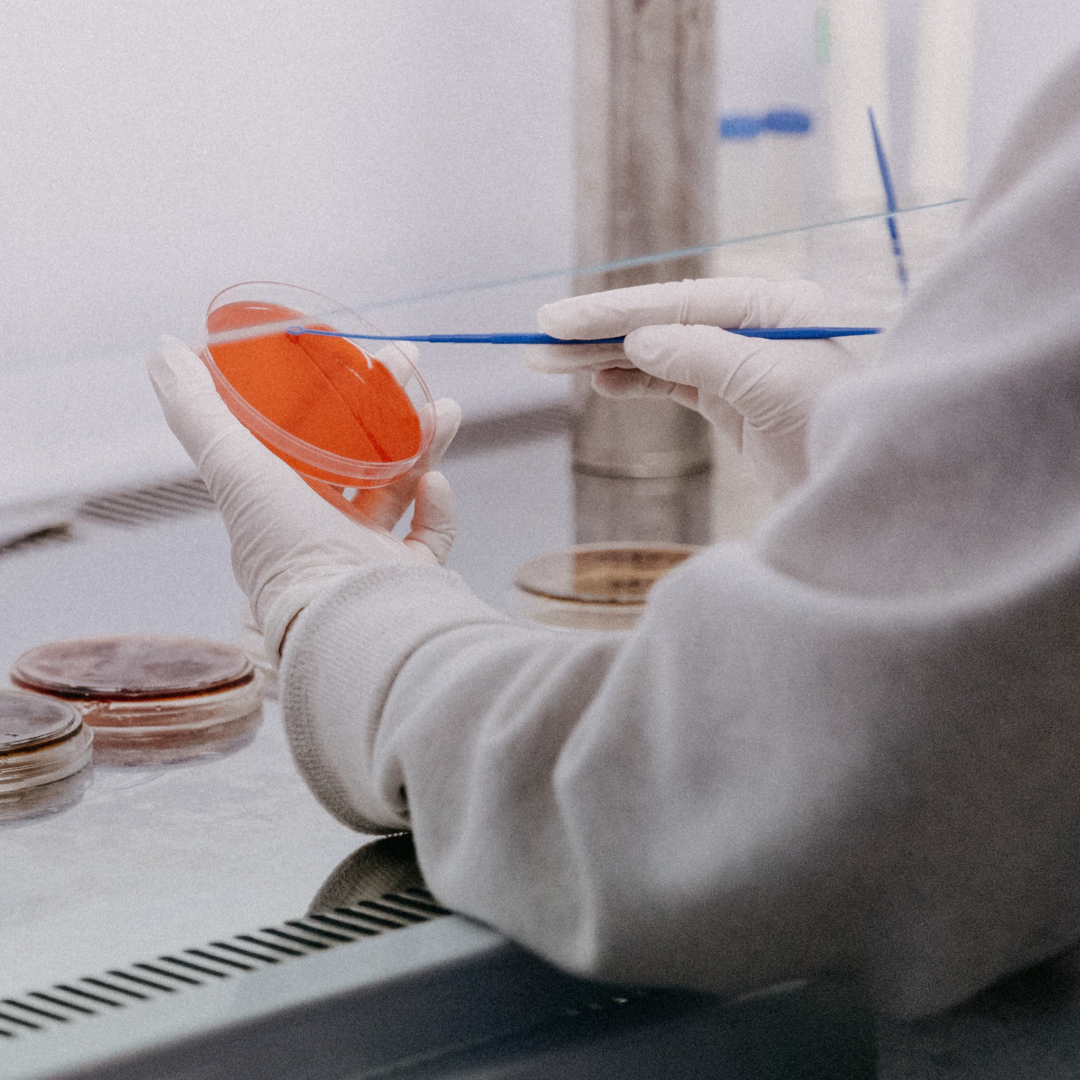

Comprometidos com o sucesso da sua marca
Terceirize sua linha de suplementos com uma indústria especializada
Transformamos sua ideia em produtos prontos para o mercado, com qualidade, segurança e conformidade com a ANVISA.
Indústria especializada em suplementos alimentares
Você está no lugar certo
Se você busca uma indústria confiável, estruturada e experiente para desenvolver e fabricar sua marca de suplementos, a BNT Farma é a escolha ideal.
Com mais de 10 anos de atuação e mais de 200 fórmulas notificadas na ANVISA, oferecemos soluções completas para empresas que desejam entrar ou crescer no mercado de suplementação.
Nossa estrutura é preparada para atender diferentes demandas, com produção em cápsulas, pós e líquidos, seguindo rigorosamente todas as normas regulatórias.
Atuamos com foco total em qualidade, eficiência produtiva e suporte estratégico para que sua marca cresça com segurança.
+10 anos de experiência
Atuação sólida na fabricação e terceirização de suplementos alimentares.
+200 fórmulas notificadas na ANVISA
Segurança, conformidade e agilidade no desenvolvimento de produtos.
Alta capacidade produtiva
Estrutura preparada para atender diferentes volumes com eficiência.
Nossas soluções em terceirização de suplementos
Desenvolvimento de produtos
Criamos formulações alinhadas às tendências de mercado, com foco em performance, saúde e inovação.
Fabricação de suplementos
Produção industrial com alto padrão de qualidade em diferentes formatos:
- Cápsulas
- Pós
- Líquidos
Produção completa (Private Label)
Cuidamos de todo o processo para que você lance sua marca com segurança e eficiência.
Consultoria para novas marcas
Apoiamos você desde a ideia até o produto final, com orientação estratégica para posicionamento no mercado.
Controle de qualidade e estabilidade
Realizamos análises rigorosas e estudos de estabilidade, garantindo segurança e confiabilidade dos produtos.
Produção e expedição
Entrega organizada, segura e dentro dos prazos para garantir o sucesso do seu negócio.
Indústria Profissional e Especializada em Suplementos
Por que escolher a BNT Farma?
01 - Estrutura Industrial Completa
Contamos com uma planta produtiva moderna, com alta capacidade e tecnologia para fabricação de suplementos em larga escala.
02 - Conformidade com a ANVISA
Todos os processos seguem rigorosamente as normas regulatórias, garantindo segurança e credibilidade para sua marca.
03 - Atendimento Especializado
Nossa equipe acompanha cada projeto de forma próxima, oferecendo suporte técnico e comercial em todas as etapas.
+10 anos
De experiência no mercado de suplementação
+200
Fórmulas notificadas na ANVISA
Alta Performance
Em produção industrial e controle de qualidade
Estrutura Completa
Em produção industrial e controle de qualidade
Como funciona a terceirização
Um processo inteligente para transformar sua ideia em produto
01. Definição
Entendemos seu projeto e definimos o melhor suplemento.
02. Aprovação
Formalizamos o processo e alinhamos todas as etapas.
03. Formulação
Desenvolvemos fórmulas seguras e aprovadas pela ANVISA.
04. Identidade
Orientamos embalagem e posicionamento da sua marca.
05. Produção
Fabricamos com alto padrão e tecnologia industrial.
06. Qualidade
Realizamos testes e estudos de estabilidade.
07. Expedição
Produto pronto para venda com logística eficiente.
Soluções completas em diferentes formatos
Produzimos suplementos em formatos estratégicos para atender diferentes públicos e posicionamentos de mercado.
Cápsulas
Ideal para suplementos de consumo diário, vitaminas e compostos funcionais.
-
✔ Alta aceitação no mercado
✔ Praticidade para o consumidor
✔ Facilidade de produção em escala
Pós
Perfeito para suplementos esportivos e produtos de alta performance.
-
✔ Whey, creatina, pré-treino e blends
✔ Alta concentração de ativos
✔ Versatilidade de sabores
Líquidos
Solução moderna com rápida absorção e diferencial competitivo.
-
✔ Multidoses e gotas
✔ Alta biodisponibilidade
✔ Forte tendência de mercado
Dê o primeiro passo para criar sua marca de suplementos
Nossa equipe comercial irá analisar sua necessidade e apresentar um plano personalizado para o desenvolvimento do seu produto.
